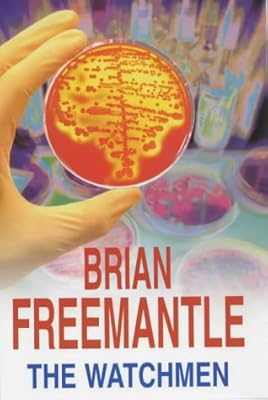
The watchmen

Readers also enjoyed
24 books
Cross and Sampson: An Alex Cross and John Sampson Thriller

First Lie Wins: A Novel

26 Beauties: A Women's Murder Club Thriller

Never Lie

The Butcher Game: A Dr. Wren Muller Novel

The Tenant

How to Solve Your Own Murder: A Novel (Castle Knoll Files Book 1)

The Silent Patient

The Widow: A Novel

The Orphanage By The Lake: A Captivating Psychological Crime Thriller With A Twist

The Thursday Murder Club: A Novel (A Thursday Murder Club Mystery)

The Last Mile

The Inmate

Cross Justice

I Am Watching You

The Fireman: A Novel

Raise The Dead

The Take

Double Exposure

Cynthia's Child

A Doctor-Nurse Encounter

The Rag Bag Clan

A Momentary Lapse of Reason

Sick as a Parrot (A Grace Smith Investigation)